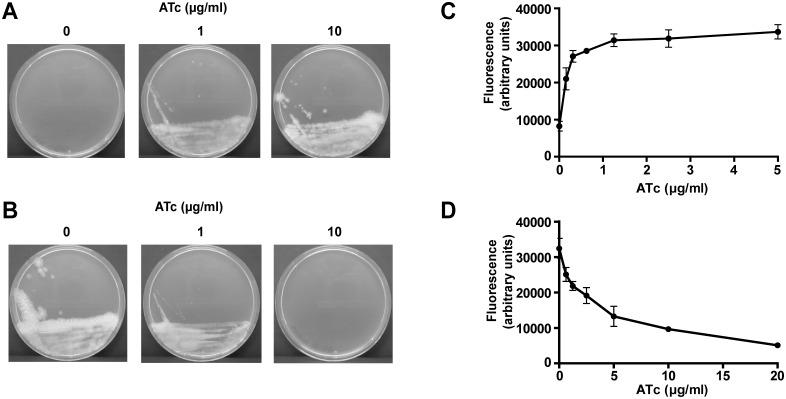
https://cdn.ncbi.nlm.nih.gov/pmc/blobs/a2fc/4418733/51425e46cfb1/pgen.1005190.g001.jpg

ESX-5分泌系统在致病性分枝杆菌外膜通透性中的重要作用。
Essential Role of the ESX-5 Secretion System in Outer Membrane Permeability of Pathogenic Mycobacteria.
作者信息
Ates Louis S, Ummels Roy, Commandeur Susanna, van de Weerd Robert, Sparrius Marion, Weerdenburg Eveline, Alber Marina, Kalscheuer Rainer, Piersma Sander R, Abdallah Abdallah M, Abd El Ghany Moataz, Abdel-Haleem Alyaa M, Pain Arnab, Jiménez Connie R, Bitter Wilbert, Houben Edith N G
机构信息
Department of Medical Microbiology and Infection Control, VU University Medical Center, Amsterdam, the Netherlands.
Institute for Medical Microbiology and Hospital Hygiene, Heinrich-Heine-University Düsseldorf, Düsseldorf, Germany.
出版信息
PLoS Genet. 2015 May 4;11(5):e1005190. doi: 10.1371/journal.pgen.1005190. eCollection 2015 May.
Mycobacteria possess different type VII secretion (T7S) systems to secrete proteins across their unusual cell envelope. One of these systems, ESX-5, is only present in slow-growing mycobacteria and responsible for the secretion of multiple substrates. However, the role of ESX-5 substrates in growth and/or virulence is largely unknown. In this study, we show that esx-5 is essential for growth of both Mycobacterium marinum and Mycobacterium bovis. Remarkably, this essentiality can be rescued by increasing the permeability of the outer membrane, either by altering its lipid composition or by the introduction of the heterologous porin MspA. Mutagenesis of the first nucleotide-binding domain of the membrane ATPase EccC5 prevented both ESX-5-dependent secretion and bacterial growth, but did not affect ESX-5 complex assembly. This suggests that the rescuing effect is not due to pores formed by the ESX-5 membrane complex, but caused by ESX-5 activity. Subsequent proteomic analysis to identify crucial ESX-5 substrates confirmed that all detectable PE and PPE proteins in the cell surface and cell envelope fractions were routed through ESX-5. Additionally, saturated transposon-directed insertion-site sequencing (TraDIS) was applied to both wild-type M. marinum cells and cells expressing mspA to identify genes that are not essential anymore in the presence of MspA. This analysis confirmed the importance of esx-5, but we could not identify essential ESX-5 substrates, indicating that multiple of these substrates are together responsible for the essentiality. Finally, examination of phenotypes on defined carbon sources revealed that an esx-5 mutant is strongly impaired in the uptake and utilization of hydrophobic carbon sources. Based on these data, we propose a model in which the ESX-5 system is responsible for the transport of cell envelope proteins that are required for nutrient uptake. These proteins might in this way compensate for the lack of MspA-like porins in slow-growing mycobacteria.
分枝杆菌拥有不同的VII型分泌(T7S)系统,用于将蛋白质分泌穿过其独特的细胞壁。这些系统之一,ESX-5,仅存在于生长缓慢的分枝杆菌中,并负责多种底物的分泌。然而,ESX-5底物在生长和/或毒力中的作用在很大程度上尚不清楚。在本研究中,我们表明esx-5对于海分枝杆菌和牛分枝杆菌的生长都是必不可少的。值得注意的是,通过改变外膜的脂质组成或引入异源孔蛋白MspA来增加外膜的通透性,可以挽救这种必需性。膜ATP酶EccC5的第一个核苷酸结合结构域的诱变阻止了ESX-5依赖性分泌和细菌生长,但不影响ESX-5复合物的组装。这表明挽救作用不是由于ESX-5膜复合物形成的孔,而是由ESX-5活性引起的。随后的蛋白质组学分析以鉴定关键的ESX-5底物,证实细胞表面和细胞壁组分中所有可检测到的PE和PPE蛋白都通过ESX-5途径运输。此外,饱和转座子导向的插入位点测序(TraDIS)应用于野生型海分枝杆菌细胞和表达mspA的细胞,以鉴定在存在MspA时不再必需的基因。该分析证实了esx-5的重要性,但我们无法鉴定必需的ESX-5底物,表明这些底物中的多个共同负责其必需性。最后,对特定碳源上的表型进行检查发现,esx-5突变体在疏水碳源的摄取和利用方面受到严重损害。基于这些数据,我们提出了一个模型,其中ESX-5系统负责运输营养摄取所需的细胞壁蛋白。这些蛋白质可能以这种方式弥补生长缓慢的分枝杆菌中缺乏MspA样孔蛋白的情况。